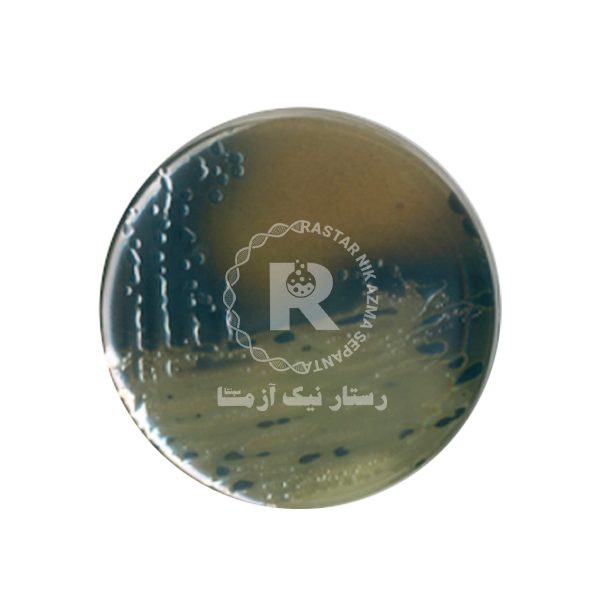
بيسموت سولفيت آگار 500گرم_كيولب

مشخصات محصول:
محیط کشت Bismuth Sulfite Agar بیسموت سولفیت آگار برای جداسازی انتخابی و شناسایی اولیه Salmonella Typhi و دیگر گونه های سالمونلا از مواد پاتولوژیک توصیه میشود . عفونت های انسانی سالمونلا اغلب ناشی از مصرف غذا، آب یا شیر آلوده به فضولات انسانی یا حیوانی است. انسان ها تنها مخزن S. Typhi هستند ، چهارنوع عفونت بالینی از سالمونلا ممکن است پدیدار شود :
مثل گاستروانتریت، باکتریمی یا سپتیسمی و تب انتریک .
Enteritidis و S. Typhimurium به طور معمول به عنوان کلنی های سیاه با پوشش شفاف فلزات ناشی از تولید سولفید هیدروژن و کاهش سولفیت به فریک سولفید سیاه ، رشد می کند. سالمونلا پاراتیفی A به عنوان کلنی های سبز روشن مشاهده میشود. در این مقاله قصد داریم علاوه بر پاسخ دادن به این سوال ها به معرفی کامل این محیط کشت پرکاربرد بپردازیم و با یکدیگر روش استفاده از آن را بررسی نمائیم. پس تا انتها همراه ما باشید.
محیط کشت بیسموت سولفیت آگار، حاصل تغییراتی در محیط تشخیصی اصلی ویلسون و بلر است که اولین بار در سال 1927 توسط این دو دانشمند ابداع شد.
محیط کشت بیسموت سولفیت آگار محیط کشتی انتخابی، جامد و افتراقی است که برای شناسایی و جداسازی اولیهی سالمونلا و بخصوص سالمونلا تیفی از بکار میرود. علت انتخابی بودن این محیط این است که از رشد میکروارگانیسم های گرم مثبت و برخی از باکتری های گرم منفی جلوگیری میکند.